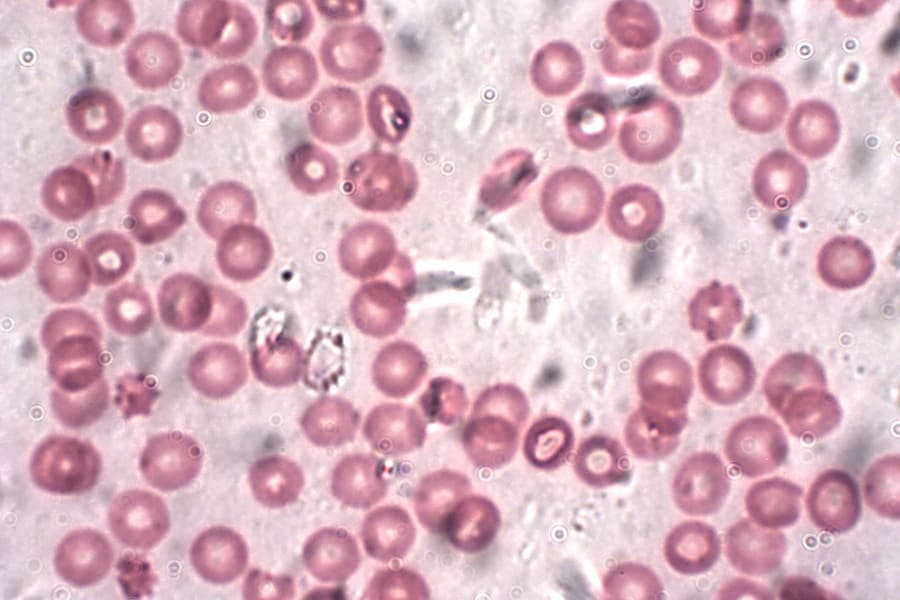

Column

Trump is making journalism great again
ColumnMarch 19, 2017
How the president endangers and strengthens journalistic practice Donald Trump’s animosity toward the press has been well-documented throughout the election campaign and his current presidency. From accusing the media of falsely reporting the size of his inauguration crowds to evicting reporters from the White House press room, President Trump has made one thing clear: he […]

Tom Dalzell documents city’s quirks and reveals an American treasure
ColumnMarch 16, 2017
Meet the man assiduously recording Berkeley’s past and present weirdness Should it ever strike your fancy to Google the terms “bowling balls as lawn art,” “enormous dachshund sculptures,” “a pyramid made of birdhouses” or “a house in the shape of a tardigrade,” you’ll be delighted to find that all these oddities exist in the city […]

Space race will foster international cooperation
ColumnMarch 13, 2017
Why it’s beneficial for countries to set their sights on reaching Mars That’s one small step for a man, one giant leap for mankind. It’s been more than 40 years, but these words remain a testament to how far countries will go to prove their superiority and how far the human race can go when […]

Double Take: Should hate speech be protected under the First Amendment?
ColumnMarch 12, 2017
YES — Taryn DeOilers The ongoing battle between alt-right firebrand Milo Yiannopoulos and left-leaning university students encapsulates the national debate on whether hate speech should continue to be safeguarded in the United States. While it’s critical to denounce the vile sentiments Yiannopoulos belches out on campuses across America, the preservation of free speech for […]

How the Constitution can check Trump
ColumnMarch 6, 2017
Checks and balances help ensure one branch of government not too powerful Since it was ratified in 1788, the United States Constitution has served as the bedrock of our nation’s democracy. As the supreme law of the land, it’s what our country turns to in times of turbulence when the way ahead seems unclear. As […]

What an awards show can say about our country
ColumnMarch 6, 2017
The Academy Awards reflected this year’s culture in a typical political fashion Following the results of the presidential election, this year’s awards season saw many celebrities taking advantage of the spotlight to speak out against America’s divided political climate and its leader, President Trump. In early January, Meryl Streep made headlines when she used her […]

Environmentalists should renew message and appeal to states
ColumnMarch 2, 2017
The environmental movement can take advantage of its lost political power Environmentalists have good reason to be sullen these days. This dear planet is tumbling unimpeded towards phosphorous depletion, ocean acidification, warmer climate and mass extinction. Developing countries are unable to tackle high birth rates and inefficient resource use. Our country, with the world’s largest […]

How technology can make healthcare more affordable
ColumnFebruary 27, 2017
New HIV, AIDS treatment has broad implications for health care A research team at the University of Nebraska Medical Center recently discovered a new pathway to open cell storage areas in the body to store antiviral drugs. The breakthrough, which uses LASER ART technology (long-acting slow effective release antiretroviral therapy), could revolutionize the way we […]

Corporate America fires back at Trump in advertisements
ColumnFebruary 26, 2017
How companies are staking out a political stance in their ads You only need to watch this year’s Super Bowl commercials to see that product ads have become increasingly political, particularly to speak out against President Trump. Corporations seized one of sport’s biggest stages to let their political preference be known. Considering that CBS charges […]
Protecting teachers unions from renewed assaults is a moral imperative
ColumnFebruary 23, 2017
A new lawsuit aims to strip crucial funds from teachers unions Teachers unions are threatened once again thanks to a new lawsuit that aims to eliminate “agency fees,” a crucial source of funding that unions often make mandatory for non-members they represent. If the lawsuit were to succeed, teachers unions would lose a significant amount […]

Question the value of private and charter schools
ColumnFebruary 20, 2017
The current administration poses a unique threat to American public education Betsy DeVos’s narrow confirmation as Secretary of Education, in which Vice President Mike Pence had to step in to break a tie, has stirred up unexpected controversy for a position that has historically been confirmed without much opposition. As a department considered less important […]

The Resurgence of Orwell’s 1984
ColumnFebruary 19, 2017
Orwell’s vision of a dystopian regime has become a bestseller after Trump’s election Kellyanne Conway, one of President Donald Trump’s chief advisors, went on NBC’s “Meet the Press” just two days after the inauguration to give an interview. When reporter Chuck Todd asked about White House Press Secretary Sean Spicer’s false claim about Trump attracting […]